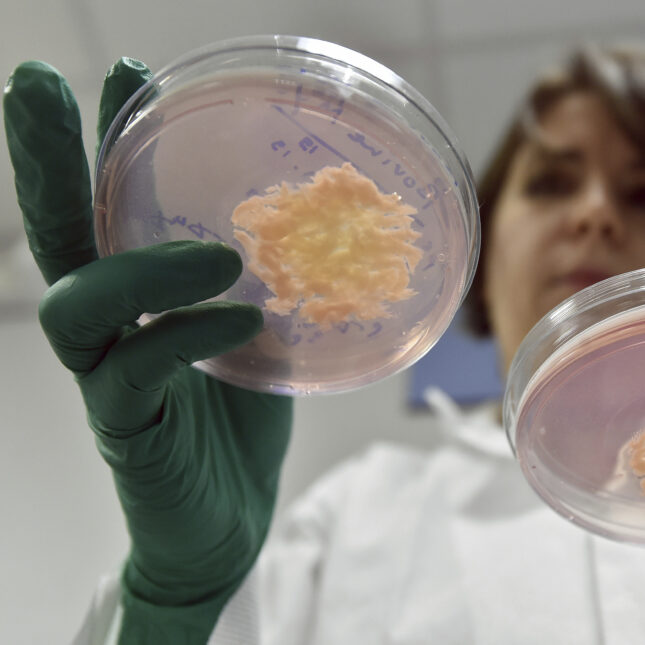
Clean Meat tweet media

Sabitlenmiş Tweet

Very excited to announce that Clean Meat News Australia is now run by @CellAgAustralia. Follow them for up-to-date news, events and opportunities in cellular agriculture.
Sign up to the newsletter here:
ow.ly/lFZi50ChtSc
English
Clean Meat
527 posts


@Cleanmeataus
A willing participant in the clean meat movement and provider of the latest Clean Meat News & Information